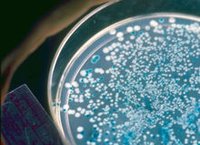
藍白斑篩選

簡介
藍白斑篩選是一種基因工程常用的重組菌篩選方法。
原理
藍白斑篩選
藍白斑篩選方面
 藍白斑篩選
藍白斑篩選操作中,添加IPTG(異丙基硫代-β-D-半乳糖苷)以激活lacz'中的β-半乳糖苷酶的啟動子,在含有X-gal的固體平板培養基中菌落呈現藍色。以上是攜帶空載體的菌株產生的表型。當外源DNA(即目的片段)與含lacz'的載體連線時,會插入進MCS(即靶基因),使α肽鏈讀碼框破壞,這種重組質粒不再表達α肽鏈,將它導入宿主缺陷菌株則無α互補作用,不產生活性β-半乳糖苷酶,即不可分解培養基中的X-gal產生藍色,培養表型即呈現白色菌落。
實驗中,通常藍白篩選是與抗性篩選一同使用的。含X-gal的平板培養基中同時含有一種或多種載體所攜帶抗性相對應的抗生素,這樣,一次篩選可以判斷出:未轉化的菌不具有抗性,不生長;轉化了空載體,即未重組質粒的菌,長成藍色菌落;轉化了重組質粒的菌,即目的重組菌,長成白色菌落。
分子生物學實驗技術
| 分子生物學(molecularbiology) 是從分子水平研究作為生命活動主要物質基礎的生物大分子結構與功能,從而闡明生命現象本質的科學。而分子生物學的各種實驗方法,是本學科得以高速發展和不斷取得突破性成就的基礎。隨著學科的發展和各相關交叉學科的進步,分子生物學實驗技術必定會越來越高效與精準,成為人類探索自然、改善自然的有力工具。 |

